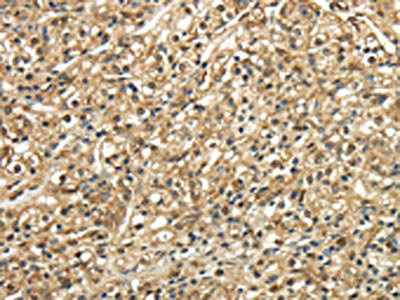

TSC22D1 Antibody
-
中文名稱:TSC22D1兔多克隆抗體
-
貨號(hào):CSB-PA993921
-
規(guī)格:¥1100
-
圖片:
-
其他:
產(chǎn)品詳情
-
Uniprot No.:
-
基因名:TSC22D1
-
別名:Cerebral protein 2 antibody; DKFZp686O19206 antibody; Hucep 2 antibody; Hucep2 antibody; KIAA1994 antibody; MGC17597 antibody; OTTHUMP00000040978 antibody; Ptg 2 antibody; Regulatory protein TSC 22 antibody; Regulatory protein TSC-22 antibody; Regulatory protein TSC22 antibody; RP11 269C23.2 antibody; T22D1_HUMAN antibody; TGFB stimulated clone 22 homolog antibody; TGFB-stimulated clone 22 homolog antibody; TGFB1I4 antibody; TGFbeta stimulated clone 22 antibody; Transcriptional regulator TSC 22 antibody; Transforming growth factor beta 1 induced transcript 4 antibody; Transforming growth factor beta 1 induced transcript 4 protein antibody; Transforming growth factor beta stimulated protein TSC 22 antibody; Transforming growth factor beta-1-induced transcript 4 protein antibody; TSC 22 antibody; TSC22 antibody; TSC22 domain family 1 isoform 2 antibody; TSC22 domain family member 1 antibody; TSC22 domain family protein 1 antibody; TSC22D1 antibody
-
宿主:Rabbit
-
反應(yīng)種屬:Human,Rat
-
免疫原:Full length fusion protein
-
免疫原種屬:Homo sapiens (Human)
-
標(biāo)記方式:Non-conjugated
-
抗體亞型:IgG
-
純化方式:Antigen affinity purification
-
濃度:It differs from different batches. Please contact us to confirm it.
-
保存緩沖液:-20°C, pH7.4 PBS, 0.05% NaN3, 40% Glycerol
-
產(chǎn)品提供形式:Liquid
-
應(yīng)用范圍:ELISA,IHC
-
推薦稀釋比:
Application Recommended Dilution ELISA 1:2000-1:5000 IHC 1:25-1:100 -
Protocols:
-
儲(chǔ)存條件:Upon receipt, store at -20°C or -80°C. Avoid repeated freeze.
-
貨期:Basically, we can dispatch the products out in 1-3 working days after receiving your orders. Delivery time maybe differs from different purchasing way or location, please kindly consult your local distributors for specific delivery time.
-
用途:For Research Use Only. Not for use in diagnostic or therapeutic procedures.
相關(guān)產(chǎn)品
靶點(diǎn)詳情
-
功能:Transcriptional repressor. Acts on the C-type natriuretic peptide (CNP) promoter.
-
基因功能參考文獻(xiàn):
- TSC22 could suppress tumor by inhibiting cell proliferation in colorectal cancer cell lines. Multivariate Cox regression analysis confirmed TSC22 expression as independent predictors of the OS in CRC patients PMID: 29481799
- TSC-22 acts as a tumor suppressor by safeguarding p53 from poly-ubiquitination mediated-degradation. PMID: 22870275
- we report that induced Tsc-22 leads to enhancement of TGF-beta-dependent signaling and enhancement is blocked by expression of a dominant-negative Tsc-22 mutant PMID: 21881999
- Differential regulation of antagonistic TSC22D1 variants is required for the establishment of oncogene-induced cellular senescence. PMID: 21448135
- Results support role of TSC22D1 as an enhancer of CNP transcription and suggest that TGF-beta-induced upregulation of CNP expression in smooth muscle may be mediated in part by increased transcription of TSC22D1. PMID: 20802130
- Long form of TSC22DF is evolutionarily conserved and has growth-regulating potential. PMID: 20149264
- Leucine Zipper structure of TSC22 markedly inhibits the anchorage independent growth of salivary gland cancer cells PMID: 11836610
- TSC-22 is an important downstream component of PPARgamma and TGF-beta signaling during intestinal epithelial cell differentiation PMID: 12468551
- findings suggest that the TSC-22 gene (-396) A allele is associated with an increasing risk of diabetic nephropathy PMID: 12757981
- Upregulation of TSC-22 mRNA by TGF-beta 1 is achieved by mRNA stabilization. PMID: 12767908
- Tsc-22 modulates the TGF-beta-dependant signaling pathway and binds to and modulate the transcriptional activity of Smad3 and Smad4. It has effect on cellular differentiation PMID: 15881652
- expression of TSC-22 in prostate is restricted to basal layer; maybe useful marker for differentation between normal and malignant acinar epithelium of prostate PMID: 16106424
- TSC-22 is a potential tumor suppressor that is upregulated by Flt3-D835V but not Flt3-ITD PMID: 17690703
- Expression of TSC-22 was frequently observed in the tumor cells with differentiated-phenotypes, although rarely in the cells with growing potentials. PMID: 18288391
- interaction between fortilin and TSC-22 prevents apoptosis via the destabilization of TSC-22 in ovarian carcinoma cells PMID: 18325344
顯示更多
收起更多
-
亞細(xì)胞定位:Cytoplasm. Nucleus.
-
蛋白家族:TSC-22/Dip/Bun family
-
組織特異性:Widely expressed in fetal and adult tissues.
-
數(shù)據(jù)庫鏈接:
Most popular with customers
-
-
-
-
-
-
-
-
VDAC1 Recombinant Monoclonal Antibody
Applications: ELISA, WB, IHC
Species Reactivity: Human, Mouse, Rat